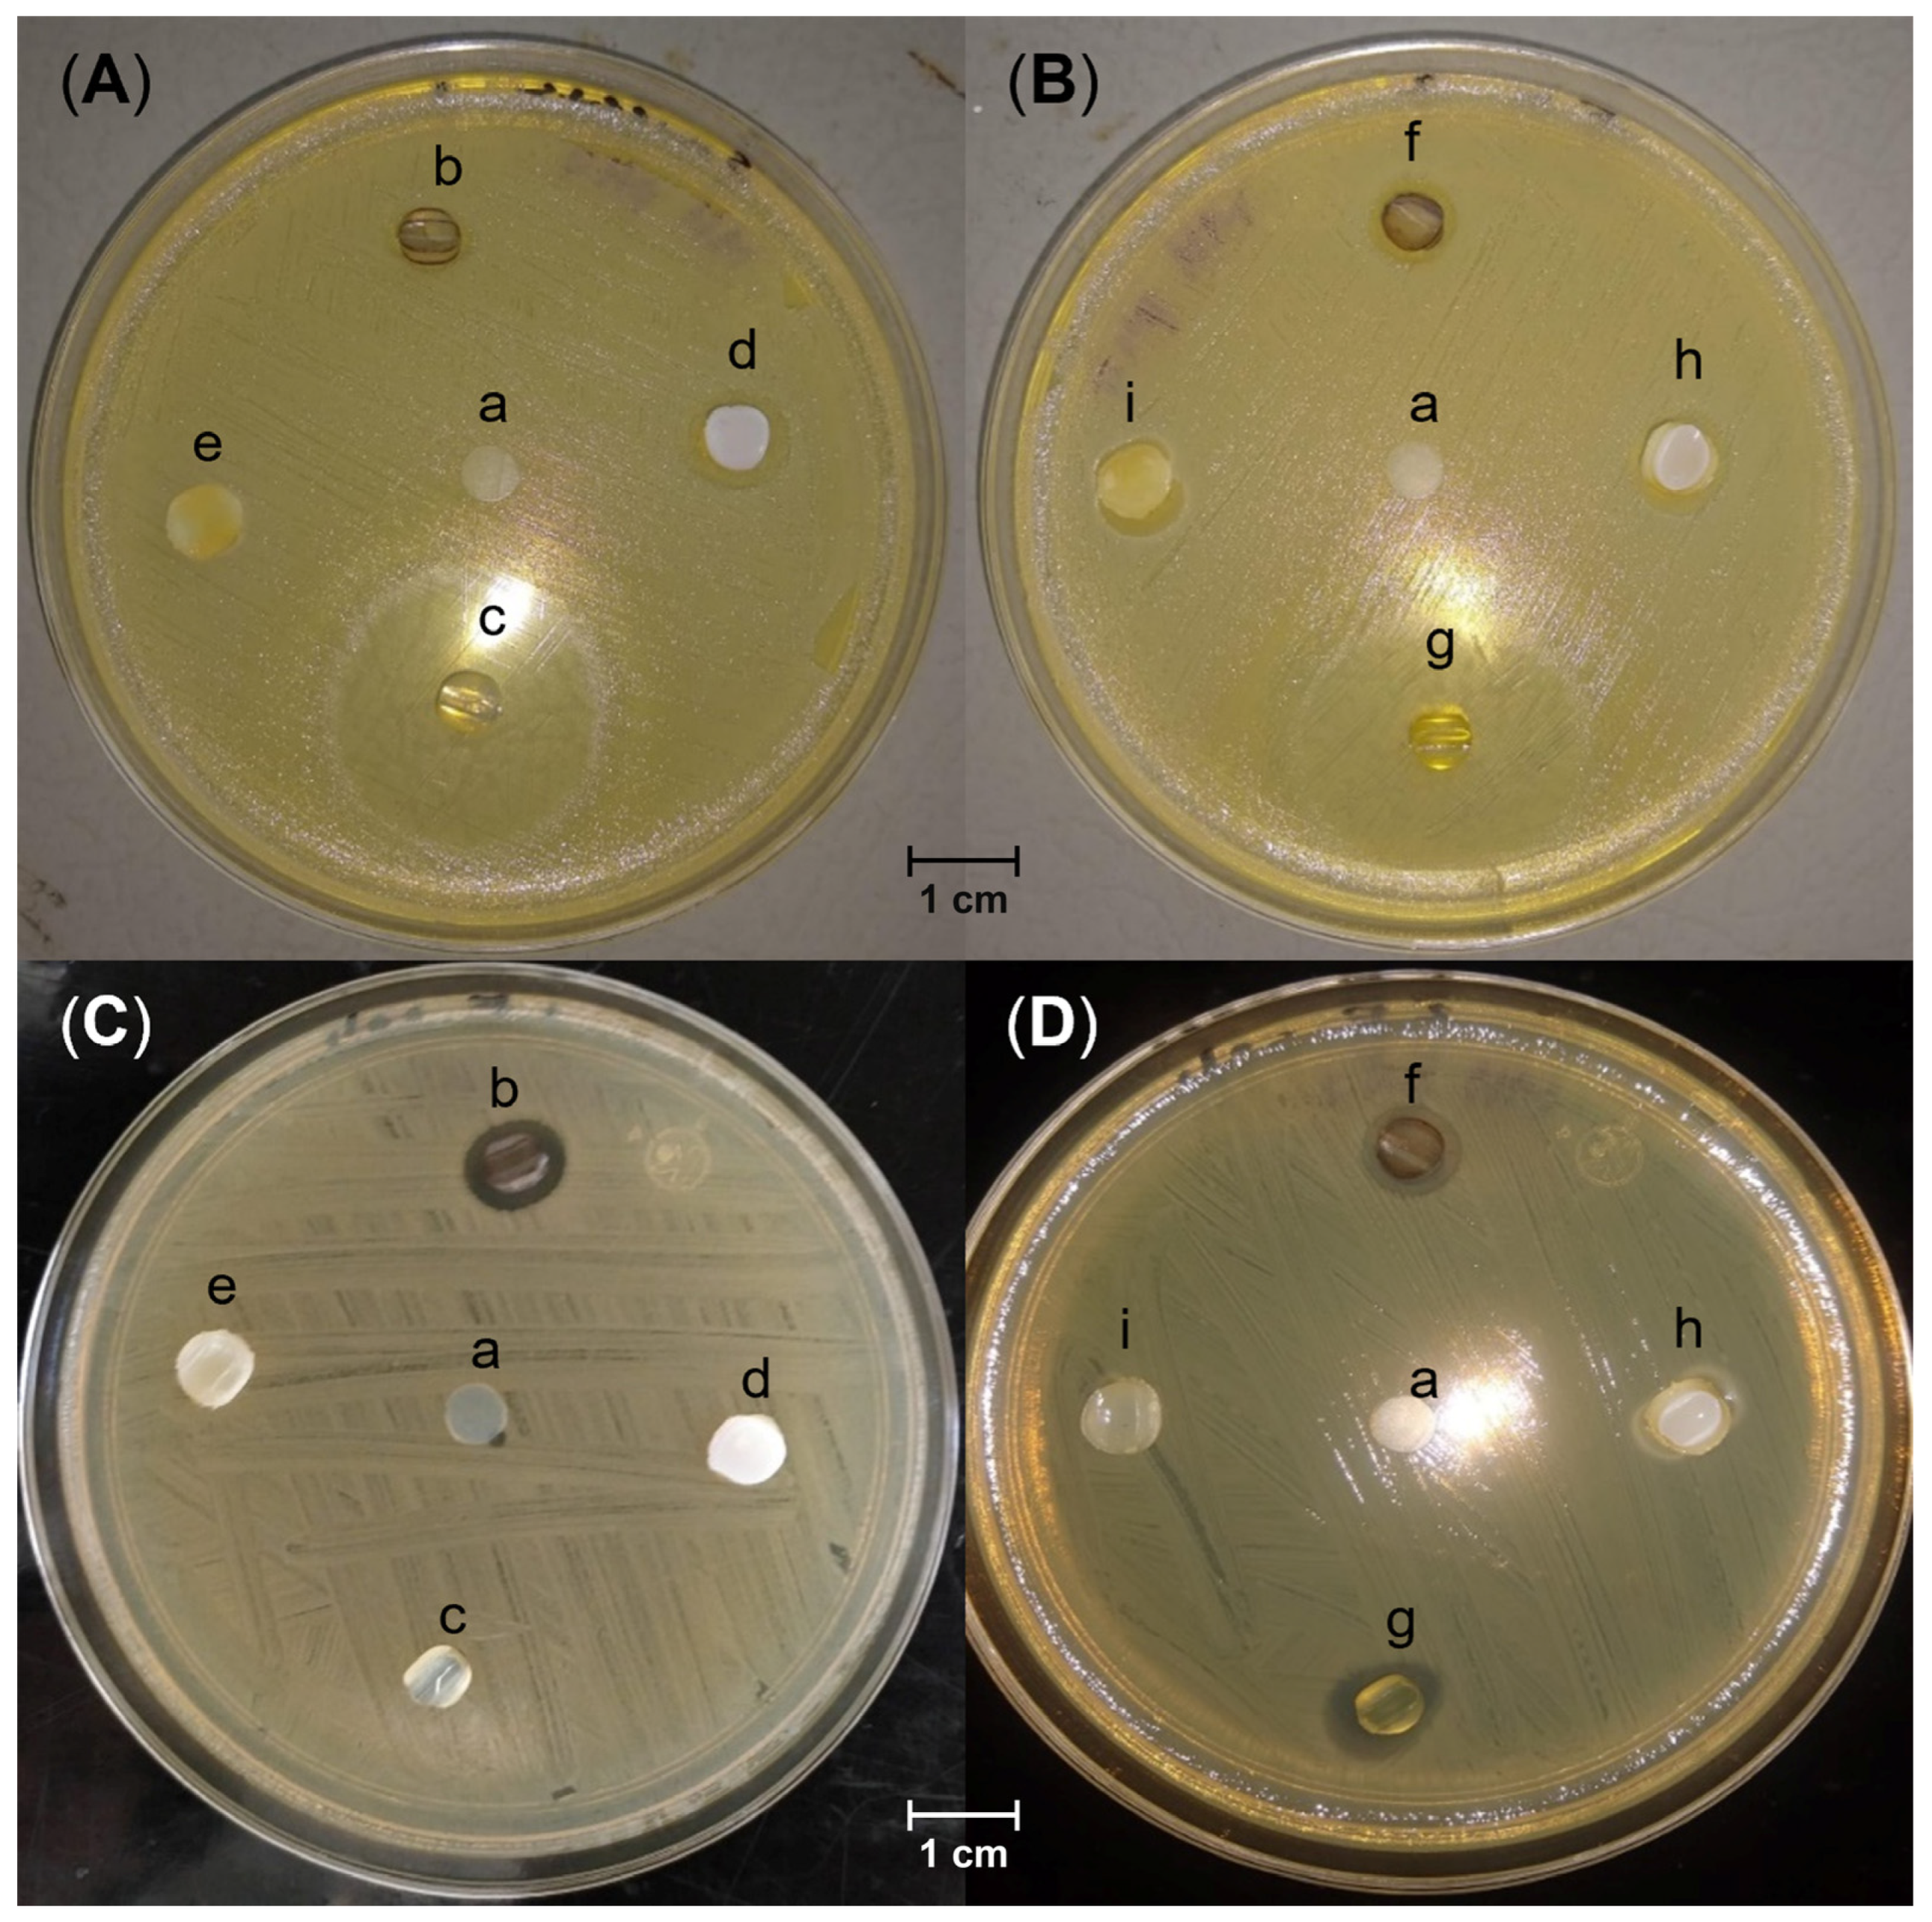
Molecules 29 02225 g008

Antimicrobial Functionalization of Silicone-graft-poly(N-vinylimidazole) Catheters
Abstract
1. Introduction
2. Results
2.1. Grafting NVI onto SC
2.2. Infrared (FTIR)
2.3. Solid-State 13C-NMR
2.4. Thermogravimetric Analysis (TGA)
2.5. Water Contact Angle
2.6. Swelling and pH Response
2.7. Antimicrobial Functionalization of SC-g-PNVI
2.8. Antimicrobial Assays in Disk
3. Discussion
4. Materials and Methods
4.1. Reagents and Solvents
4.2. Equipment and Instruments
4.3. Synthesis of SC-g-PNVI
- wg = final weight of the grafted catheter;
- w0 = initial weight of the pristine catheter.
4.4. Characterization of SC-g-PNVI
4.4.1. Experimental Details of Contact Angle
4.4.2. Experimental Details of TGA
4.4.3. Experimental Details of Limit Swelling
- ws = weight of the swollen sample;
- w0 = weight of the dry sample.
4.5. Functionalization of SC-g-PNVI with Ag
- (%)@Ag = residue (%) at 800 °C of the sample loaded with Ag;
- (%) = residue (%) at 800 °C of the sample without Ag.
4.6. Quaternization of SC-g-PNVI with Iodomethane and Bromoethane
- Q(%) = quaternization degree;
- w exp halide = experimental weight of the halide compound;
- w theo halide = theoretical weight of the halide compound.
4.7. Ampicillin Loading
4.8. Ampicillin Release
4.9. Kirby–Bauer Disk Diffusion Susceptibility Test
5. Conclusions
Supplementary Materials
Author Contributions
Funding
Institutional Review Board Statement
Informed Consent Statement
Data Availability Statement
Acknowledgments
Conflicts of Interest
References
- Schuh, J.C.L.; Funk, K.A. Compilation of International Standards and Regulatory Guidance Documents for Evaluation of Biomaterials, Medical Devices, and 3-D Printed and Regenerative Medicine Products. Toxicol. Pathol. 2019, 47, 344–357. [Google Scholar] [CrossRef] [PubMed]
- Gad, S.C. Standards and Methods for Assessing the Safety and Biocompatibility of Biomaterials. In Characterization of Biomaterials; Jaffe, M., Hammond, W., Tolias, P., Arinzeh, T., Eds.; Elsevier: Amsterdam, The Netherlands, 2013; pp. 285–306. [Google Scholar]
- Pinson, J.; Thiry, D. Surface Modification of Polymers; Pinson, J., Thiry, D., Eds.; Wiley-VCH: Hoboken, NJ, USA, 2019; ISBN 9783527345410. [Google Scholar]
- Smith, J.R.; Lamprou, D.A. Polymer Coatings for Biomedical Applications: A Review. Trans. IMF 2014, 92, 9–19. [Google Scholar] [CrossRef]
- Arthur, D.E.; Jonathan, A.; Ameh, P.O.; Anya, C. A Review on the Assessment of Polymeric Materials Used as Corrosion Inhibitor of Metals and Alloys. Int. J. Ind. Chem. 2013, 4, 1–9. [Google Scholar] [CrossRef]
- Zander, Z.K.; Becker, M.L. Antimicrobial and Antifouling Strategies for Polymeric Medical Devices. ACS Macro Lett. 2018, 7, 16–25. [Google Scholar] [CrossRef]
- Kocak, G.; Tuncer, C.; Bütün, V. PH-Responsive Polymers. Polym. Chem. 2017, 8, 144–176. [Google Scholar] [CrossRef]
- Cao, H.; Qiao, S.; Qin, H.; Jandt, K.D. Antibacterial Designs for Implantable Medical Devices: Evolutions and Challenges. J. Funct. Biomater. 2022, 13, 86. [Google Scholar] [CrossRef]
- Wassil, S.K.; Crill, C.M.; Phelps, S.J. Antimicrobial Impregnated Catheters in the Prevention of Catheter-Related Bloodstream Infection in Hospitalized Patients. J. Pediatr. Pharmacol. Ther. 2007, 12, 77–90. [Google Scholar] [CrossRef]
- Al-Qahtani, M.; Safan, A.; Jassim, G.; Abadla, S. Efficacy of Anti-Microbial Catheters in Preventing Catheter Associated Urinary Tract Infections in Hospitalized Patients: A Review on Recent Updates. J. Infect. Public Health 2019, 12, 760–766. [Google Scholar] [CrossRef]
- Jacobsen, S.M.; Stickler, D.J.; Mobley, H.L.T.; Shirtliff, M.E. Complicated Catheter-Associated Urinary Tract Infections Due to Escherichia Coli and Proteus Mirabilis. Clin. Microbiol. Rev. 2008, 21, 26–59. [Google Scholar] [CrossRef]
- Zagaglia, C.; Ammendolia, M.G.; Maurizi, L.; Nicoletti, M.; Longhi, C. Urinary Tract Infections Caused by Uropathogenic Escherichia Coli Strains—New Strategies for an Old Pathogen. Microorganisms 2022, 10, 1425. [Google Scholar] [CrossRef]
- Malanoski, G.J. Staphylococcus Aureus Catheter-Associated Bacteremia. Arch. Intern. Med. 1995, 155, 1161. [Google Scholar] [CrossRef] [PubMed]
- Chaves, F.; Garnacho-Montero, J.; del Pozo, J.L.; Bouza, E.; Capdevila, J.A.; de Cueto, M.; Domínguez, M.Á.; Esteban, J.; Fernández-Hidalgo, N.; Fernández Sampedro, M.; et al. Diagnosis and Treatment of Catheter-Related Bloodstream Infection: Clinical Guidelines of the Spanish Society of Infectious Diseases and Clinical Microbiology and (SEIMC) and the Spanish Society of Spanish Society of Intensive and Critical Care Medicine a. Med. Intensiv. 2018, 42, 5–36. [Google Scholar] [CrossRef] [PubMed]
- Langford, B.J.; Daneman, N.; Diong, C.; Lee, S.M.; Fridman, D.J.; Johnstone, J.; MacFadden, D.; Mponponsuo, K.; Patel, S.N.; Schwartz, K.L.; et al. Antibiotic Selection and Duration for Catheter-Associated Urinary Tract Infection in Non-Hospitalized Older Adults: A Population-Based Cohort Study. Antimicrob. Steward. Healthc. Epidemiol. 2023, 3, e132. [Google Scholar] [CrossRef] [PubMed]
- Trautner, B.W. Management of Catheter-Associated Urinary Tract Infection. Curr. Opin. Infect. Dis. 2010, 23, 76–82. [Google Scholar] [CrossRef] [PubMed]
- Elwood, R.L.; Spencer, S.E. Successful Clearance of Catheter-Related Bloodstream Infection by Antibiotic Lock Therapy Using Ampicillin. Ann. Pharmacother. 2006, 40, 347–350. [Google Scholar] [CrossRef] [PubMed]
- Franci, G.; Falanga, A.; Galdiero, S.; Palomba, L.; Rai, M.; Morelli, G.; Galdiero, M. Silver Nanoparticles as Potential Antibacterial Agents. Molecules 2015, 20, 8856–8874. [Google Scholar] [CrossRef] [PubMed]
- Dizaj, S.M.; Lotfipour, F.; Barzegar-Jalali, M.; Zarrintan, M.H.; Adibkia, K. Antimicrobial Activity of the Metals and Metal Oxide Nanoparticles. Mater. Sci. Eng. C 2014, 44, 278–284. [Google Scholar] [CrossRef] [PubMed]
- Zhang, H.; Wang, T.; Fan, L.; Liu, X.; Dong, Y.; Chen, M.; Wang, Y.; Zhang, Q.; Zou, Y. Quaternization Cross-Linking of Hyperbranched Polyethylene-Graft-Poly(Diethylaminoethyl Methacrylate) as Antimicrobial Separation Layer of Molecular Sieving Membrane. J. Memb. Sci. 2024, 692, 122313. [Google Scholar] [CrossRef]
- Şen, F.; Kocatürk, E.; Çakmakçı, E.; Kahraman, M.V. Quaternary Imidazolium-Functionalized Reactive Silica Nanoparticles-Containing Thiol-Ene Photocured Antibacterial Hybrid Coatings. React. Funct. Polym. 2022, 170, 105149. [Google Scholar] [CrossRef]
- Zare, M.; Ghomi, E.R.; Venkatraman, P.D.; Ramakrishna, S. Silicone-Based Biomaterials for Biomedical Applications: Antimicrobial Strategies and 3D Printing Technologies. J. Appl. Polym. Sci. 2021, 138, e50969. [Google Scholar] [CrossRef]
- Nasef, M.M.; Gupta, B.; Shameli, K.; Verma, C.; Ali, R.R.; Ting, T.M. Engineered Bioactive Polymeric Surfaces by Radiation Induced Graft Copolymerization: Strategies and Applications. Polymers 2021, 13, 3102. [Google Scholar] [CrossRef] [PubMed]
- Naikwadi, A.T.; Sharma, B.K.; Bhatt, K.D.; Mahanwar, P.A. Gamma Radiation Processed Polymeric Materials for High Performance Applications: A Review. Front. Chem. 2022, 10, 837111. [Google Scholar] [CrossRef] [PubMed]
- Liu, Y.; Han, Y.; Wu, Y.; Xiong, L.; Hang, T.; Ling, H.; Hu, A.; Gao, L.; Li, M. Grafting of Poly(Methacrylic Acid-Co-Acrylamide) Film on Silicon Surface via a Simultaneous Hydrolysis Process. Mater. Today Commun. 2019, 21, 100678. [Google Scholar] [CrossRef]
- Meléndez-Ortiz, H.I.; Alvarez-Lorenzo, C.; Burillo, G.; Magariños, B.; Concheiro, A.; Bucio, E. Radiation-Grafting of N-Vinylimidazole onto Silicone Rubber for Antimicrobial Properties. Radiat. Phys. Chem. 2015, 110, 59–66. [Google Scholar] [CrossRef]
- Magennis, E.P.; Hook, A.L.; Williams, P.; Alexander, M.R. Making Silicone Rubber Highly Resistant to Bacterial Attachment Using Thiol-Ene Grafting. ACS Appl. Mater. Interfaces 2016, 8, 30780–30787. [Google Scholar] [CrossRef] [PubMed]
- Montoya-Villegas, K.A.; Ramírez-Jiménez, A.; Zizumbo-López, A.; Pérez-Sicairos, S.; Leal-Acevedo, B.; Bucio, E.; Licea-Claverie, A. Controlled Surface Modification of Silicone Rubber by Gamma-Irradiation Followed by RAFT Grafting Polymerization. Eur. Polym. J. 2020, 134, 109817. [Google Scholar] [CrossRef]
- Flores-Rojas, G.G.; Pino-Ramos, V.H.; López-Saucedo, F.; Concheiro, A.; Alvarez-Lorenzo, C.; Bucio, E. Improved Covalent Immobilization of Lysozyme on Silicone Rubber-Films Grafted with Poly(Ethylene Glycol Dimethacrylate-Co-Glycidylmethacrylate). Eur. Polym. J. 2017, 95, 27–40. [Google Scholar] [CrossRef]
- Santillán-González, B.; Duarte-Peña, L.; Bucio, E. Binary Graft of Poly(Acrylic Acid) and Poly(Vinyl Pyrrolidone) onto PDMS Films for Load and Release of Ciprofloxacin. Polymers 2023, 15, 302. [Google Scholar] [CrossRef] [PubMed]
- Magaña, H.; Becerra, C.D.; Serrano-Medina, A.; Palomino, K.; Palomino-Vizcaíno, G.; Olivas-Sarabia, A.; Bucio, E.; Cornejo-Bravo, J.M. Radiation Grafting of a Polymeric Prodrug onto Silicone Rubber for Potential Medical/Surgical Procedures. Polymers 2020, 12, 1297. [Google Scholar] [CrossRef]
- Elzahaby, D.A.; Farrag, H.A.; Haikal, R.R.; Alkordi, M.H.; Abdeltawab, N.F.; Ramadan, M.A. Inhibition of Adherence and Biofilm Formation of Pseudomonas Aeruginosa by Immobilized ZnO Nanoparticles on Silicone Urinary Catheter Grafted by Gamma Irradiation. Microorganisms 2023, 11, 913. [Google Scholar] [CrossRef]
- Ramirez-Fuentes, M.U.; Duarte-Peña, L.; Bucio, E. Drug Delivery in Thermo-Responsive Silicone Catheters by Grafting of N-Vinylcaprolactam Using Gamma Radiation. MRS Commun. 2024. [Google Scholar] [CrossRef]
- Kutcherlapati, S.R.; Koyilapu, R.; Jana, T. Poly( N-Vinyl Imidazole) Grafted Silica Nanofillers: Synthesis by RAFT Polymerization and Nanocomposites with Polybenzimidazole. J. Polym. Sci. A Polym. Chem. 2018, 56, 365–375. [Google Scholar] [CrossRef]
- Png, Z.M.; Wang, C.-G.; Yeo, J.C.C.; Lee, J.J.C.; Surat’man, N.E.; Tan, Y.L.; Liu, H.; Wang, P.; Tan, B.H.; Xu, J.W.; et al. Stimuli-Responsive Structure–Property Switchable Polymer Materials. Mol. Syst. Des. Eng. 2023, 8, 1097–1129. [Google Scholar] [CrossRef]
- Liu, K.-J.; Gregor, H.P. Metal-Polyelectrolyte Complexes. X. Poly-N-Vinylimidazole Complexes with Zinc(II) and with Copper(II) and Nitrilotriacetic Acid. J. Phys. Chem. 1965, 69, 1252–1259. [Google Scholar] [CrossRef]
- Mudassir, M.A.; Hussain, S.Z.; Rehman, A.; Zaheer, W.; Asma, S.T.; Jilani, A.; Aslam, M.; Zhang, H.; Ansari, T.M.; Hussain, I. Development of Silver-Nanoparticle-Decorated Emulsion-Templated Hierarchically Porous Poly(1-Vinylimidazole) Beads for Water Treatment. ACS Appl. Mater. Interfaces 2017, 9, 24190–24197. [Google Scholar] [CrossRef]
- Hou, W.-C.; Stuart, B.; Howes, R.; Zepp, R.G. Sunlight-Driven Reduction of Silver Ions by Natural Organic Matter: Formation and Transformation of Silver Nanoparticles. Environ. Sci. Technol. 2013, 47, 7713–7721. [Google Scholar] [CrossRef]
- Azaceta, E.; Marcilla, R.; Sanchez-Diaz, A.; Palomares, E.; Mecerreyes, D. Synthesis and Characterization of Poly(1-Vinyl-3-Alkylimidazolium) Iodide Polymers for Quasi-Solid Electrolytes in Dye Sensitized Solar Cells. Electrochim. Acta 2010, 56, 42–46. [Google Scholar] [CrossRef]
- Mazzei, I.R.; Nikolaeva, D.; Fuoco, A.; Loïs, S.; Fantini, S.; Monteleone, M.; Esposito, E.; Ashtiani, S.J.; Lanč, M.; Vopička, O.; et al. Poly[3-Ethyl-1-Vinyl-Imidazolium] Diethyl Phosphate/Pebax® 1657 Composite Membranes and Their Gas Separation Performance. Membranes 2020, 10, 224. [Google Scholar] [CrossRef]
- Molina, M.J.; Gómez-Antón, M.R.; Piérola, I.F. Factors Driving the Protonation of Poly( N -vinylimidazole) Hydrogels. J. Polym. Sci. B Polym. Phys. 2004, 42, 2294–2307. [Google Scholar] [CrossRef]
- Ganapathi, P.; Ganesan, K.; Dharmasivam, M.; Alam, M.M.; Mohammed, A. Efficient Antibacterial Dimeric Nitro Imidazolium Type of Ionic Liquids from a Simple Synthetic Approach. ACS Omega 2022, 7, 44458–44469. [Google Scholar] [CrossRef]
- Korsmeyer, R.W.; Peppas, N.A. Effect of the Morphology of Hydrophilic Polymeric Matrices on the Diffusion and Release of Water Soluble Drugs. J. Memb. Sci. 1981, 9, 211–227. [Google Scholar] [CrossRef]
- Torres, S.F.; Iolster, T.; Schnitzler, E.J.; Siaba Serrate, A.J.; Sticco, N.A.; Rocca Rivarola, M. Hypotonic and Isotonic Intravenous Maintenance Fluids in Hospitalised Paediatric Patients: A Randomised Controlled Trial. BMJ Paediatr. Open 2019, 3, e000385. [Google Scholar] [CrossRef]

Disclaimer/Publisher’s Note: The statements, opinions and data contained in all publications are solely those of the individual author(s) and contributor(s) and not of MDPI and/or the editor(s). MDPI and/or the editor(s) disclaim responsibility for any injury to people or property resulting from any ideas, methods, instructions or products referred to in the content. |
© 2024 by the authors. Licensee MDPI, Basel, Switzerland. This article is an open access article distributed under the terms and conditions of the Creative Commons Attribution (CC BY) license (https://creativecommons.org/licenses/by/4.0/).
Share and Cite
Navarrete-Germán, L.E.; Gómez-Lázaro, B.; López-Saucedo, F.; Bucio, E. Antimicrobial Functionalization of Silicone-graft-poly(N-vinylimidazole) Catheters. Molecules 2024, 29, 2225. https://doi.org/10.3390/molecules29102225
Navarrete-Germán LE, Gómez-Lázaro B, López-Saucedo F, Bucio E. Antimicrobial Functionalization of Silicone-graft-poly(N-vinylimidazole) Catheters. Molecules. 2024; 29(10):2225. https://doi.org/10.3390/molecules29102225
Chicago/Turabian StyleNavarrete-Germán, Luis Enrique, Belén Gómez-Lázaro, Felipe López-Saucedo, and Emilio Bucio. 2024. "Antimicrobial Functionalization of Silicone-graft-poly(N-vinylimidazole) Catheters" Molecules 29, no. 10: 2225. https://doi.org/10.3390/molecules29102225
APA StyleNavarrete-Germán, L. E., Gómez-Lázaro, B., López-Saucedo, F., & Bucio, E. (2024). Antimicrobial Functionalization of Silicone-graft-poly(N-vinylimidazole) Catheters. Molecules, 29(10), 2225. https://doi.org/10.3390/molecules29102225

